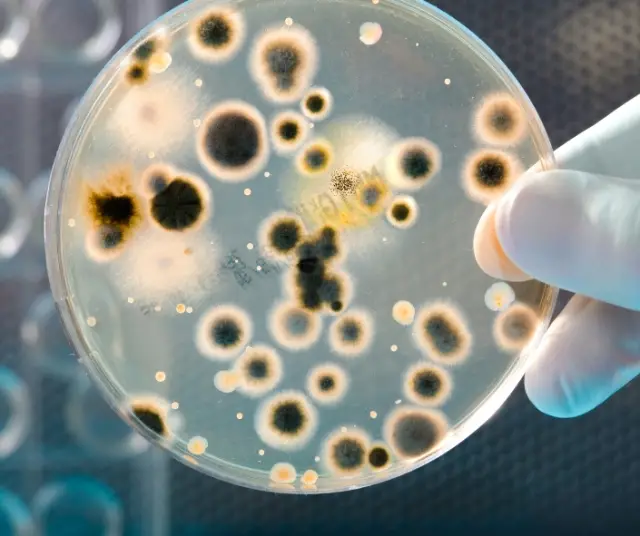
Flesh-Eating Bacteria: An Invisible Threat

In recent years, there has been growing concern surrounding a bacterium known as " flesh-eating bacterium " or Vibrio infection. These bacteria, especially Vibrio vulnificus , can cause serious and life-threatening infections in humans. Explore what flesh-eating bacteria is, how it is contracted, the symptoms it produces, and the prevention measures needed to protect ourselves from this invisible threat.
What is flesh-eating bacteria?
Flesh-eating bacteria , also known as Vibrio infection or Vibrio vulnificus, is a gram-negative bacterium that can cause serious infections in humans. This bacterium is commonly found in salty and warm waters, such as lakes, rivers, and seas.
Vibrio vulnificus can enter the human body in a number of ways, the most common being through the consumption of infected raw or undercooked shellfish, or by coming into contact with contaminated water that contains the bacteria. It can also enter through open wounds on the skin while in the water, such as cuts, scrapes, or insect bites.
Once inside the body, the bacteria can cause different types of infections, such as gastrointestinal illnesses or skin infections. Symptoms may vary depending on the route of entry and the general health of the individual. Some of the common symptoms include nausea, vomiting, diarrhea, abdominal pain, redness, swelling, blistering, and severe pain around a wound or injury. In severe cases, the infection can lead to sepsis, a life-threatening systemic inflammatory response.
It is important to note that infection by the flesh-eating bacteria is relatively rare, and most healthy people are not affected. However, people with weakened immune systems, chronic illnesses, or underlying medical conditions are at higher risk of developing serious complications.
How do you get the infection?
Infection with the flesh-eating bacteria is usually acquired by coming into contact with contaminated water or by consuming infected raw or undercooked shellfish . It is also possible to get the infection through open wounds on the skin by coming into contact with contaminated water, such as wounds caused by cuts, scrapes, or insect bites while in the water.
symptoms and complications
The symptoms of Vibrio vulnificus infection can vary depending on the route of entry of the bacteria and the general health of the individual. Common symptoms may include:
Gastrointestinal disease: nausea, vomiting, diarrhea and abdominal pain.
Skin infection: redness, swelling, blistering, and severe pain around a wound or injury.
Sepsis: fever, chills, fatigue, shortness of breath, and low blood pressure. Sepsis is a serious complication that can be life-threatening and requires immediate medical attention.
In severe cases, infection by the flesh-eating bacteria can lead to necrosis of the affected tissues, which can result in amputation of the affected limb or even death.
Prevention and security measures
To protect yourself from flesh-eating bacteria, the following prevention and safety measures should be followed:
Properly Cook Shellfish: Be sure to cook shellfish, such as shrimp, oysters, and mussels, to a temperature high enough to kill bacteria. Avoid eating raw or undercooked shellfish, especially if you have a weakened immune system or an underlying medical condition.
Avoid contaminated water: Avoid swimming in contaminated water or water of unknown quality, especially if you have open skin wounds. Always consult public health warnings and advice before swimming in natural bodies of water.
Maintain good hygiene: Wash your hands regularly with soap and water before eating and after coming into contact with salt water or raw shellfish.
Protect wounds: If you have an open wound, avoid coming into contact with salty or polluted water. Cover wounds with waterproof dressings or bandages before entering the water.
Consult a doctor: If you experience symptoms of infection, such as redness or swelling around a wound or gastrointestinal illness after consuming shellfish, seek immediate medical attention. Early detection and proper treatment can prevent serious complications.
If you experience symptoms of infection, seek medical attention immediately. With awareness and caution, we can reduce the risk of contracting flesh-eating bacteria infection and stay safe while enjoying the delights of seafood and water activities.